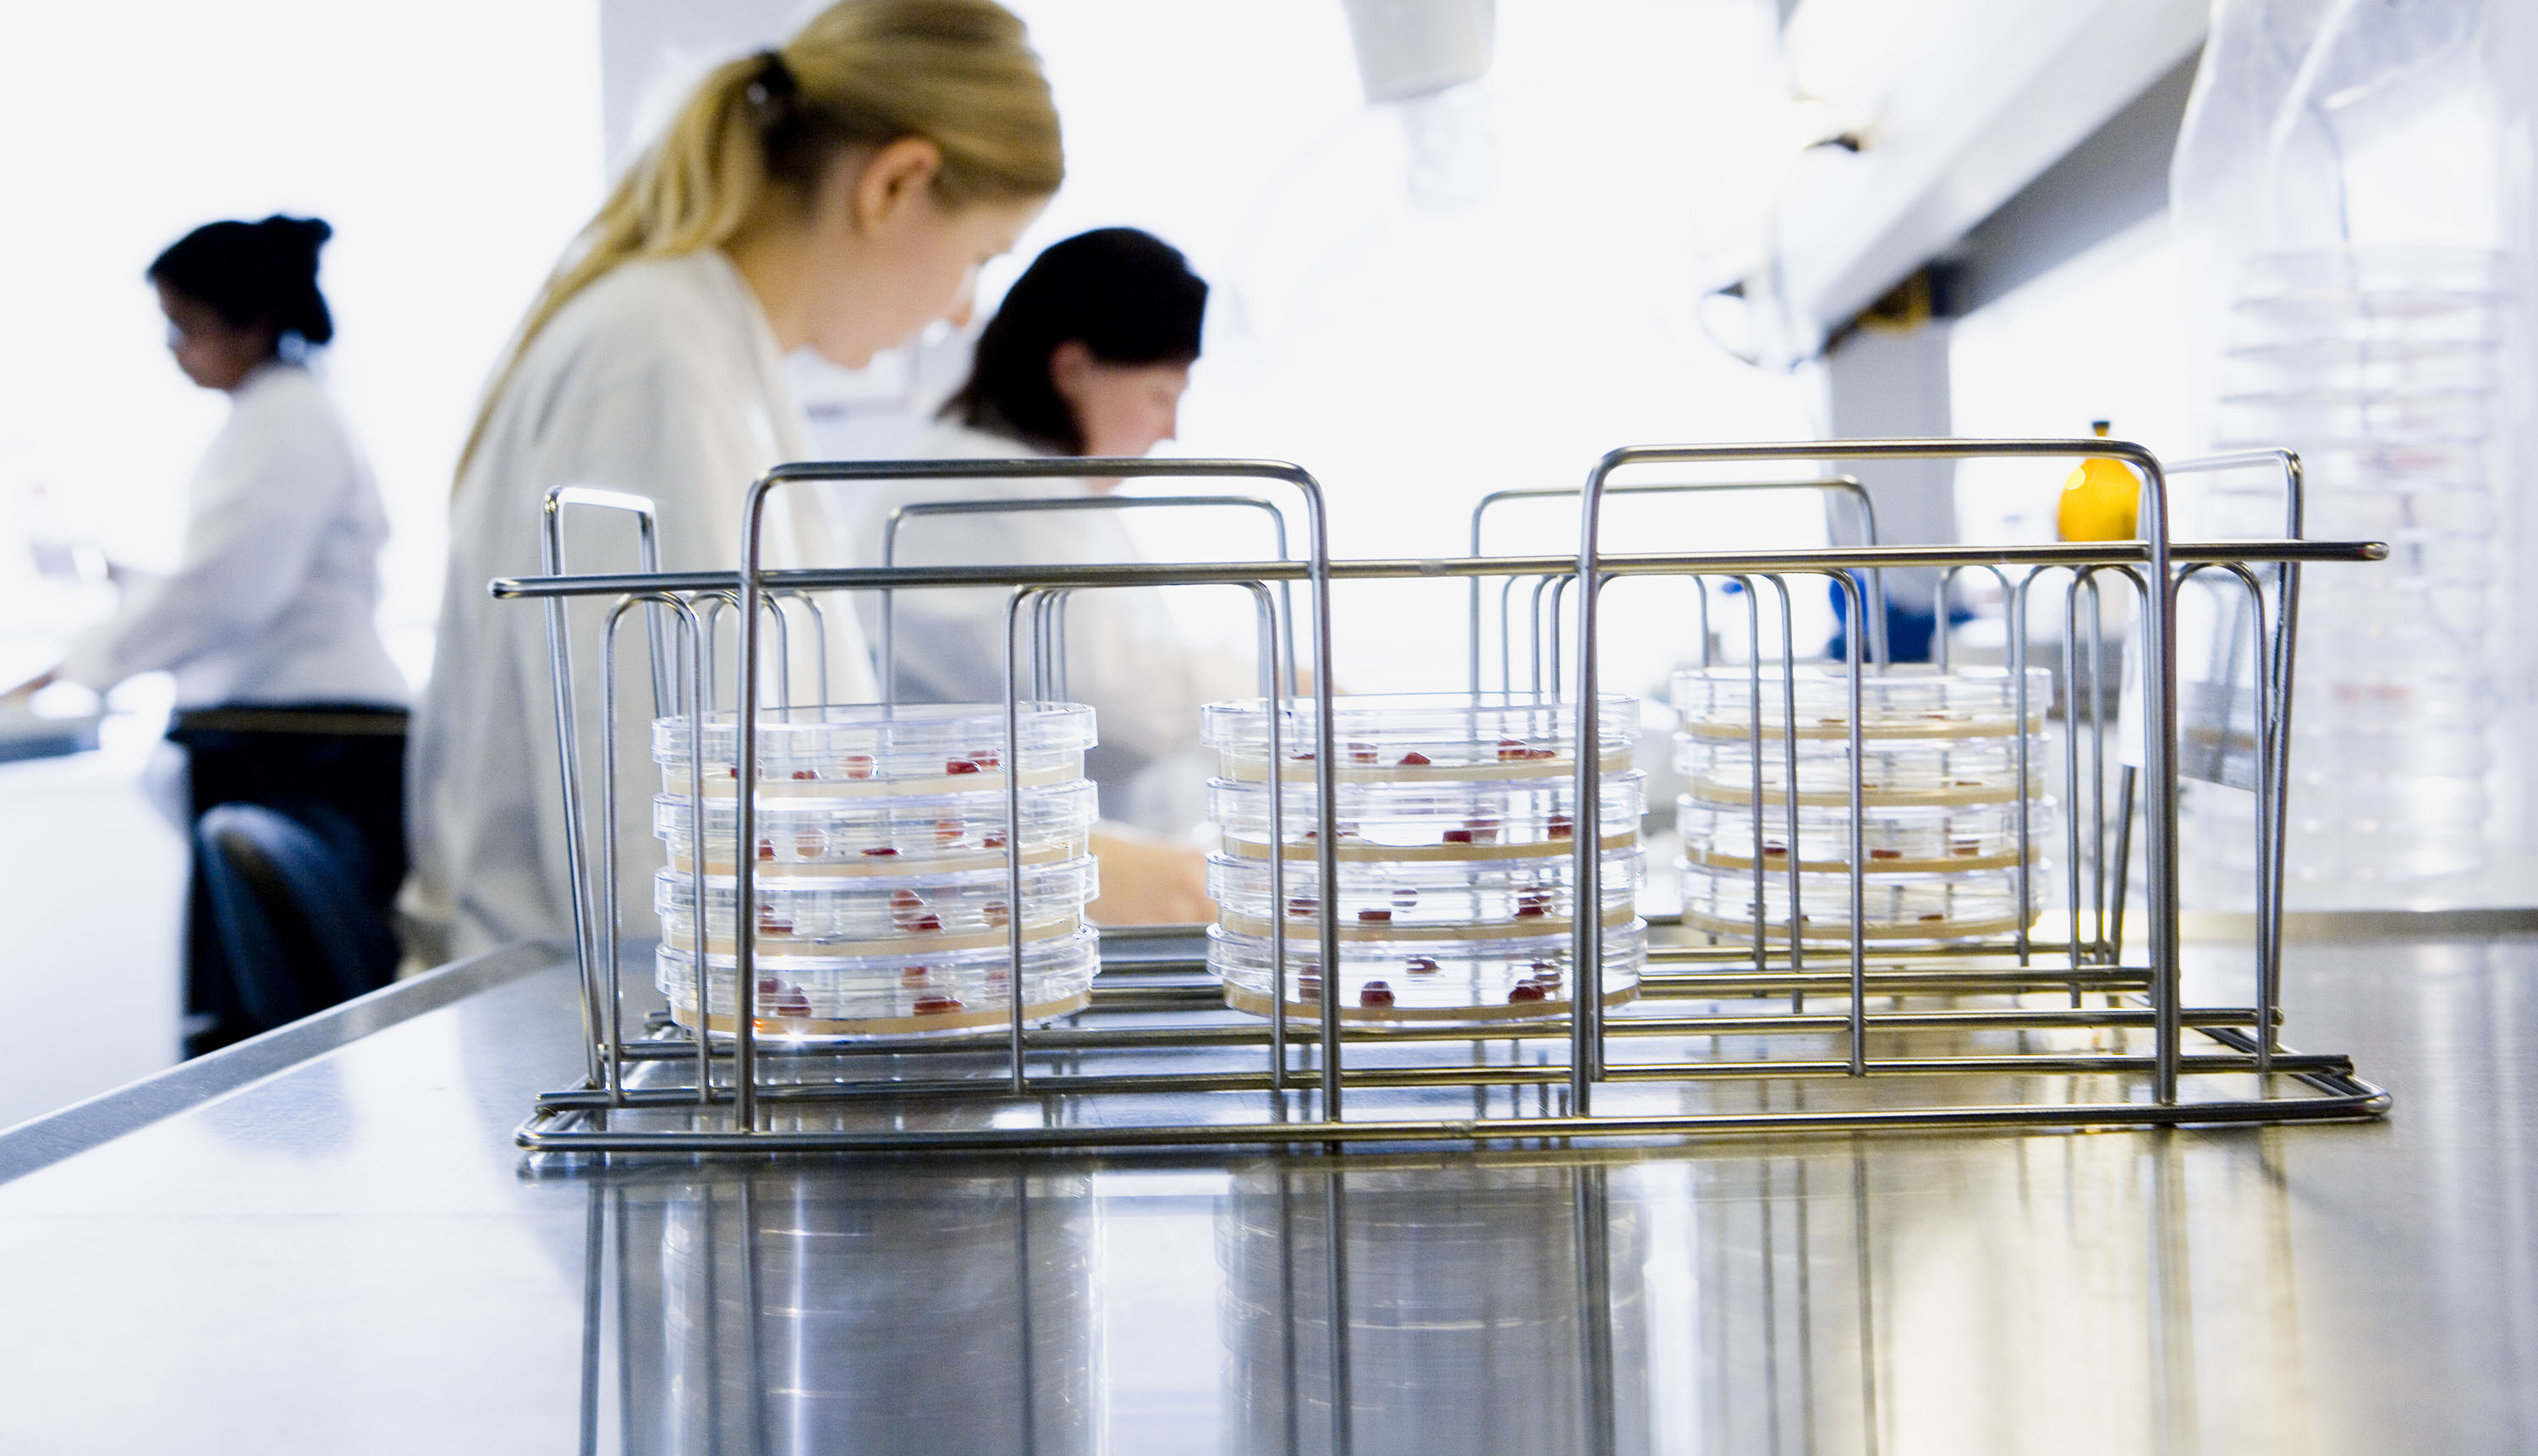

Slagtesvinebesætninger overvåges for forekomst af Salmonella ved undersøgelse af kødsaftprøver, der udtages på slagteriet. Alle prøver undersøges på samme laboratorium, og det har desværre vist sig, at salmonellaværdierne af kødsaftprøver analyseret fra 23. august 2019 til nu har været for høje. Der bliver indført en kontrol-procedure for at undgå en sådan fejl fremover. For nogle besætninger betyder det, at salmonellaindekset er for højt, da nogle af de prøver, der reelt var negative pga. stigningen, er blevet dømt positive. Ovenstående har desværre medført, ca. 50 besætninger i hver af månederne september og oktober 2019 er kommet i niveau 2 eller 3 på forkert grundlag.
Tiltag er aftalt mellem myndigheder og branche
Det er ved hjælp af en række udvidede beregninger blevet fastslået, hvor meget salmonellaværdierne har ligget for højt, og det er beregnet, at der skal trækkes 7 fra salmonellaværdierne. Således vil en prøve, der har salmonellaværdien 17 blive korrigeret til værdien 10. Det vil sige, den kommer under 11, som er grænsen for, at en prøve dømmes positiv.
Alle resultater af kødsaftprøver analyseret fra 23. august 2019 vil blive rettet, og de korrekte værdier vil blive overført til salmonelladatabasen. Disse rettelser vil blive foretaget ved en kørsel fredag den 8. november 2019. De nye og korrekte resultater er tilgængelige i løbet af den 9. november 2019. Desuden er besætninger, der fejlagtigt var placeret i niveau 3 ved niveau-udpegningen i oktober måned allerede flyttet til det korrekte niveau. De øvrige besætninger får ikke ændret niveau.
Alle besætninger, der i september og oktober måneder har været placeret i forkert niveau, vil blive kontrolleret og fejlagtigt trukket salmonella-fradrag vil blive refunderet.
De beregnede slagtesvineindeks for september og oktober måneder bliver ikke beregnet på ny.